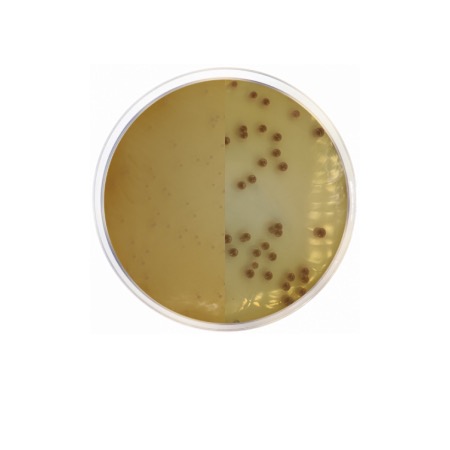
product
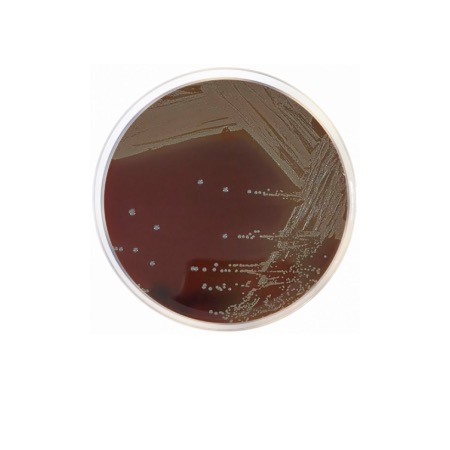
product

The formulation of GC Broth is designed to meet the demanding nutritional requirements of "GC" (Gonococcus) group organisms. It contains a specialized Peptone Mixture that provides a rich source of nitrogen, amino acids, and long-chain peptides. Corn Starch is included to neutralize toxic fatty acids that may be present in the medium or the inoculum, which would otherwise inhibit the growth of sensitive Neisseria species. Sodium Chloride maintains osmotic equilibrium, while a robust Phosphate Buffering System (Dipotassium and Monopotassium Phosphate) ensures a stable pH during bacterial metabolism. This medium is frequently used as a base that can be further enriched with growth supplements to maximize the recovery of fastidious strains.
Advantages
- Optimized for Fastidious Pathogens: Specifically balanced to support the growth of the most demanding clinical isolates.
- Neutralizing Properties: Starch content effectively protects cultures from inhibitory metabolic byproducts and fatty acids.
- Strong Buffering Capacity: Stabilizes the pH, which is critical for the survival of Neisseria species during the growth phase.
- High Sensitivity: Facilitates the detection of pathogens even when present in low concentrations within the sample.
- Versatile Base: Can be supplemented with hemoglobin, vitamins, or antimicrobial agents to create selective enrichment environments.
Technical specifications
| Catalogue number |
2075 |
| Brand |
Condalab |
| Application |
Cultivation of fastidious Neisseria and Haemophilus |
| Typical Composition (g/L) |
Peptone Mixture (15.0); Corn Starch (1.0); Dipotassium Phosphate (4.0); Monopotassium Phosphate (1.0); Sodium Chloride (5.0) |
| Final pH (at 25 °C) |
7.2 ± 0.2 |
| Preparation |
36.0 g/L |
| Storage Temperature |
2 – 25 °C |
Available packaging options
| 2075 |
500 g plastic bottle |